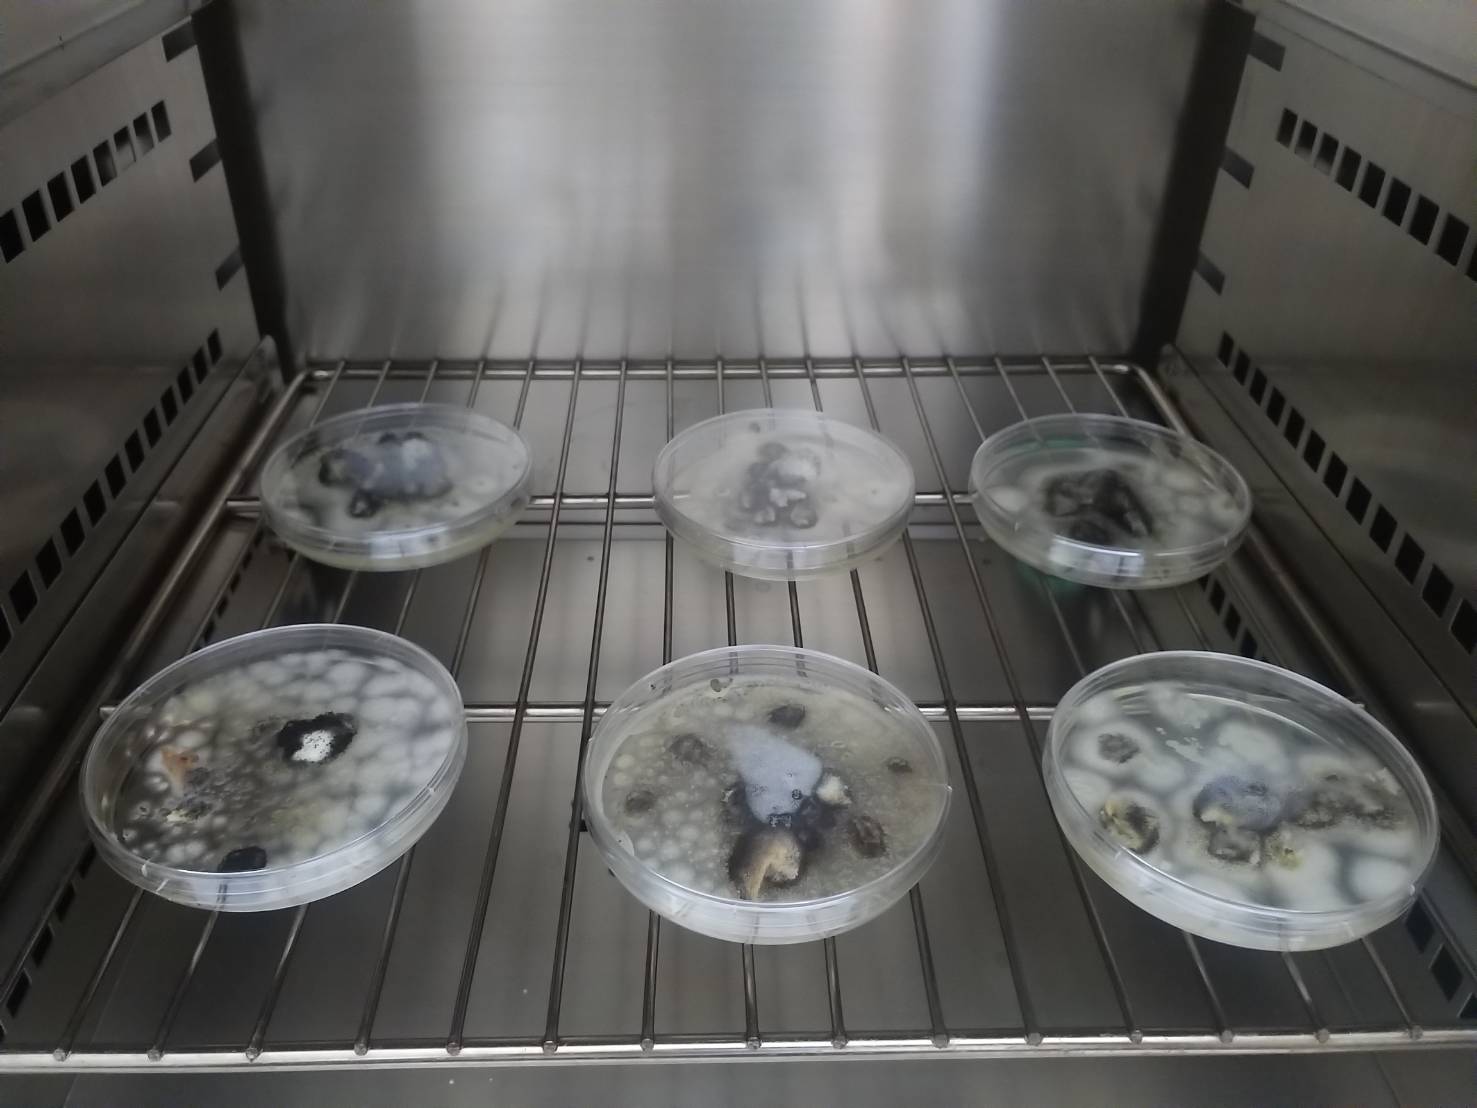

發布時間:2021/08/09 11:11 點閱數:983

織品類文物從古至今被大量使用,從古代宮廷、神社廟寺、神明繡衣到族群祭典皆可發現大量使用的蹤跡,足以紀錄其當代工藝及文化沿革。尤以宗教信仰之旗幡掛布或垂掛式織品中,出現的咒文及信仰圖像,像是賦予神秘力量及祈福解厄,甚至成為與神靈間溝通的媒介係為最神秘暨重要的一環。臺灣廟宇宗教信仰風氣相當盛行,像是「北港飛龍團大龍旗」及「神明的穿戴文化」所呈現地位及不同職責,臺灣廟宇文化資產可稱為在地文化的靈魂所在。在廟宇常見到一些織品文物襯托著充滿當代歷史或典故的裝飾藝術文化,其作品包羅萬象涵蓋神話、宗教、民間傳說、歷史典故、日常文物等等,具祈福、勸世、教化人心等意義,更加反映了臺灣早期社會文化價值與宗教信仰的內涵。而織品文物污染或污漬常深入內部結構中,需利用較為侵略性之手段才能淡化或移除,進而容易破壞本身之結構成分造成脆化或斷裂的現象。因此,織品文物清潔修護之面向思考可以採用黏性大、具可自主設計(滿足文物本身材料)且適合織品文物兼以環保優先的綠色化學-離子液體。
本計畫設計織品文物(絲棉材質)修復常見亦較為棘手之污染進行修復清潔材料的研發,其設計三種污染物,有機污染物(煙燻產物),廟宇中文物長期受到線香之煙燻影響,使其失去原有之美且逐漸暗淡;無機污染物(鐵鏽類),金屬材質且容易殘留生鏽漬跡於織品文物上,形成修復上較難以移除的污染;黴菌斑污染(生物性污染保存過程),黴菌孢子更容易孳生且引來蟲害影響,致使整個文物被蟲害啃食殆盡,再利用所開發之離子液體進行清潔測試並與先前研究比較其差異性。
目前初步成果,已完成三種織品試片之污染物(有機污染、無機污染、生物性污染),以及初步配置完成2種離子液體(1-丁基-3-甲基咪唑四氟硼酸鹽[BMIM][BF4]及1-丁基-3-甲基咪唑六氟磷酸鹽[BMIM][PF6]。後續階段研究,開始進行2種離子液體在不同的污染物試片清潔測試並與凝膠法(檸檬酸、硼酸、二乙基三胺五乙酸(DTPA)、乙二胺四乙酸(EDTA)、抗壞血酸及不同pH濃度)效果進行比較,期獲得更佳的清潔修復方式,使文物更能延續其價值及保存意義。最後將其所有研究成果與應用層面進行評估,提供予相關管理單位及相關修復單位重要的參考依據及防護措施新選項並創造雙贏。
撰寫單位:正修學校財團法人正修科技大學